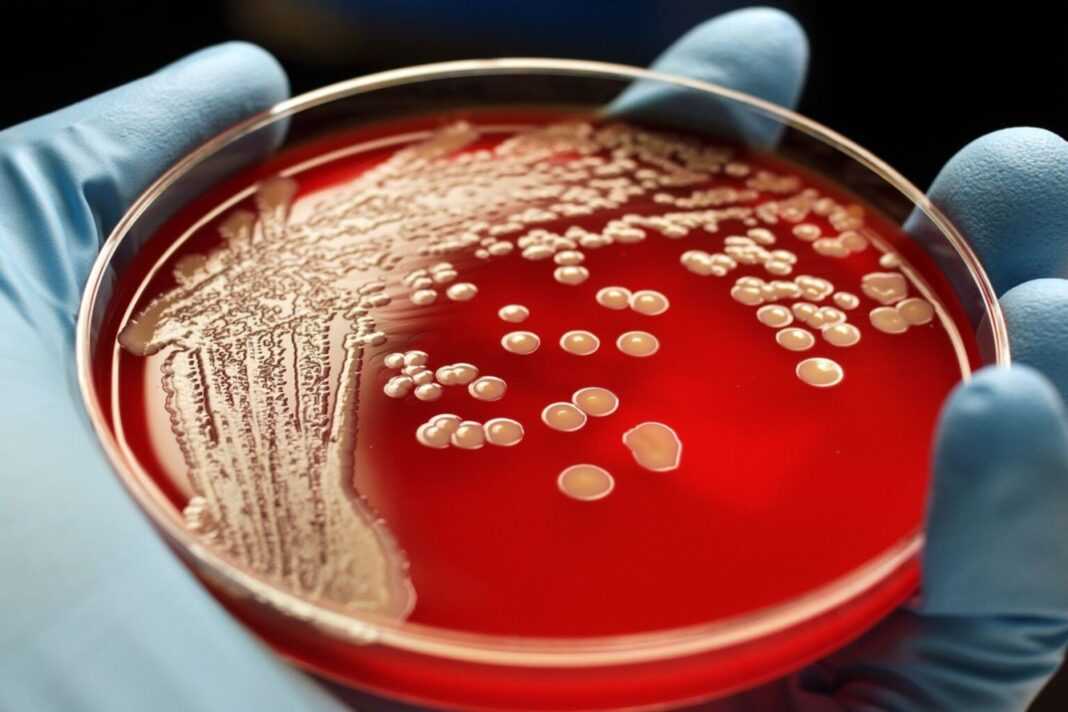

Κοινός ένοχος λοιμώξεων του δέρματος και του αναπνευστικού, ο Staphylococcus aureus είναι εξαιρετικά απρόβλεπτος. Μεταξύ 20 και 30% των ανθρώπων φέρουν ήσυχες αποικίες στο δέρμα τους και στα ρουθούνια τους, οι οποίες σπάνια προκαλούν προβλήματα πέρα από το περιστασιακό εξάνθημα. Αλλά σε ορισμένες περιπτώσεις αυτά τα βακτήρια προκαλούν λοιμώξεις που οδηγούν σε θανατηφόρες επιπλοκές, όπως πνευμονία, βαθιές λοιμώξεις του δέρματος και σήψη. Μέχρι πρόσφατα, δεν υπήρχε τρόπος να προβλεφθεί ποιες λοιμώξεις θα έπαιρναν θανατηφόρο τροπή. Τώρα, μια νέα μελέτη περιγράφει μεταλλάξεις που προδιαθέτουν τους ασθενείς σε σοβαρές σταφυλοκοκκικές λοιμώξεις. Η έρευνα, που δημοσιεύτηκε στο Science, εντοπίζει ένα μεταλλαγμένο γονίδιο κοινό σε πολλούς ασθενείς που πάσχουν από απειλητικές για τη ζωή λοιμώξεις σταφυλόκοκκου και υποδηλώνει ότι άτομα που ζουν με μια γενετική πάθηση γνωστή ως σύνδρομο 5p- ή Cri-du-chat μπορεί να διατρέχουν παρόμοιο κίνδυνο.

“Έχουμε χαρακτηρίσει σοβαρή λοίμωξη από Staphylococcus aureus σε γενετικό, κυτταρικό, ανοσολογικό και κλινικό επίπεδο”, λέει ο András Spaan, πρώτος συγγραφέας της μελέτης. “Με την ενσωμάτωση αυτών των επιπέδων, δημιουργήσαμε την αιτιότητα και παρέχουμε ενδείξεις για μελλοντικές παρεμβάσεις.” Για να κατανοήσουν καλύτερα γιατί το S. aureus προκαλεί νόσο σε μερικούς ανθρώπους αλλά όχι σε άλλους, επιστήμονες στο εργαστήριο του ανοσολόγου Ροκφέλερ Jean-Laurent Casanova εξέτασαν τα πρωτεϊνικά γονιδιώματα περισσότερων από 100 ασθενών που είχαν υποφέρει από ανεξήγητες σοβαρές λοιμώξεις από σταφυλόκοκκο. Το κοινό γενετικό νήμα που συνδέει μερικούς από αυτούς τους διαφορετικούς ασθενείς ήταν μεταλλάξεις ενός γονιδίου που ονομάζεται OTULIN, το οποίο βρίσκεται σκαρφαλωμένο κατά μήκος του κοντού βραχίονα του χρωμοσώματος 5 και κωδικοποιεί ένα ένζυμο που εμπλέκεται στη ρύθμιση της φλεγμονής.
Αυτά τα άτομα δεν στερήθηκαν εντελώς το OTULIN – μόνο ένα από τα δύο αντίγραφά τους του γονιδίου ήταν μεταλλαγμένο – αλλά αυτή η ανεπάρκεια φαινόταν ότι ήταν το μόνο που χρειαζόταν για να τα καταστήσει ευάλωτα σε λοιμώξεις που μετά βίας θα έβλαπταν άλλους ανθρώπους. Οι επιστήμονες περίμεναν να ανακαλύψουν ότι η ανεπάρκεια OTULIN με κάποιο τρόπο ακρωτηριάζει τα λευκά αιμοσφαίρια ή με άλλο τρόπο εμποδίζει το ανοσοποιητικό σύστημα να καταπνίξει το S. aureus. Αλλά περαιτέρω έρευνα αποκάλυψε ότι αυτές οι μεταλλάξεις προκαλούν έμμεσα τη συσσώρευση μιας άσχετης πρωτεΐνης στις επιφάνειες των κυττάρων του δέρματος και των πνευμόνων, συσσωρεύοντας τα εργαλεία που χρησιμοποιούν αυτά τα κύτταρα για να αμυνθούν από μια τοξίνη που παράγεται από το S. aureus. Αυτός ο μηχανισμός άμυνας είναι γνωστός ως κυτταρική ενδογενής ανοσία.
Αυτό το εύρημα ήταν ιδιαίτερα εκπληκτικό, διότι μέχρι τότε, συγκεκριμένα ελαττώματα στην εγγενή ανοσία των κυττάρων είχαν συνδεθεί μόνο με την προδιάθεση για ορισμένες ιογενείς λοιμώξεις, από την COVID έως τον έρπητα και την εγκεφαλίτιδα. Ποτέ δεν είχε αποδειχθεί ότι παίζει ρόλο στη βακτηριακή νόσο. “Αυτή είναι η πρώτη γνωστή περίπτωση κυτταρικής ενδογενούς ανοσοανεπάρκειας που προδιαθέτει τους ασθενείς σε βακτηριακή λοίμωξη”, λέει ο Spaan. Ενώ στα άτομα που μελέτησαν ο Spaan και οι συνεργάτες του έλειπε μόνο ένα αντίγραφο του OTULIN, τα άτομα που γεννήθηκαν χωρίς κανένα λειτουργικό αντίγραφο αυτού του γονιδίου αντιμετωπίζουν μια σειρά από πρώιμες φλεγμονώδεις νόσους, οι οποίες συχνά αποδεικνύονται θανατηφόρες τον πρώτο χρόνο της ζωής τους.
Αυτή η παρατήρηση οδήγησε τον Spaan στο συμπέρασμα ότι ένα λειτουργικό αντίγραφο του OTULIN είναι αρκετό για την πρόληψη της φλεγμονώδους νόσου, αλλά ανεπαρκές για την προστασία από απειλητικές για τη ζωή λοιμώξεις από σταφυλόκοκκο – ένας γενετικός μηχανισμός γνωστός ως απλοανεπάρκεια. “Ο γενετικός μηχανισμός ήταν σημαντικό να εντοπιστεί”, λέει ο Spaan. “Τα άτομα με δύο λειτουργικά αντίγραφα του γονιδίου φαίνεται να είναι υγιή, όσοι δεν έχουν λειτουργικά αντίγραφα έχουν αυτοφλεγμονώδη νόσο και όσοι έχουν ένα λειτουργικό αντίγραφο είναι επιρρεπή σε σοβαρές λοιμώξεις από σταφυλόκοκκο”. Δεδομένου αυτού του γενικού κανόνα, οι ερευνητές υπέθεσαν ότι οποιοσδήποτε πληθυσμός του λείπει μόνο ένα αντίγραφο του OTULIN θα είχε παρόμοια προδιάθεση για σοβαρές λοιμώξεις. Έτσι, στη συνέχεια εξέτασαν μια ομάδα εθελοντών με σύνδρομο 5p-, την πιο κοινή διαταραχή χρωμοσωμικής διαγραφής στους ανθρώπους που χαρακτηρίζεται από αναπτυξιακές καθυστερήσεις, νοητικές αναπηρίες και στα βρέφη, ένα έντονο κλάμα.
Στους περισσότερους ασθενείς με σύνδρομο 5p- λείπει ολόκληρος ο βραχύς βραχίονας του χρωμοσώματος 5 και ως εκ τούτου συνεχίζουν πάντα τη ζωή τους με ένα μόνο λειτουργικό αντίγραφο του OTULIN. Πράγματι, κατά την εξέταση έξι ασθενών με σύνδρομο 5p-, η ομάδα διαπίστωσε ότι το ένα τρίτο ήταν ευαίσθητο σε πνευμονικές λοιμώξεις. “Καταφέραμε να αποδείξουμε ότι αυτή η ευαισθησία οφείλεται στο γεγονός ότι είχαν μόνο ένα λειτουργικό αντίγραφο του OTULIN”, λέει ο Spaan. “Από πολλούς τρόπους, αυτοί οι ασθενείς έμοιαζαν γενετικά με τους ασθενείς που είχαμε εντοπίσει με σοβαρές λοιμώξεις από σταφυλόκοκκο. Τόσο κλινικά όσο και σε κυτταρικό επίπεδο, θα μπορούσαμε σχεδόν να πούμε ότι έχουν την ίδια ασθένεια”. Τα ευρήματα δεν υπονοούν ότι όλοι με απλοανεπάρκεια OTULIN ή σύνδρομο 5p- θα προσβληθούν από σοβαρές λοιμώξεις. Στην πραγματικότητα, τα αρχικά αποτελέσματα της μελέτης πρότειναν ότι μόνο το 30 τοις εκατό των ατόμων με αυτές τις μεταλλάξεις αναπτύσσουν σοβαρή ασθένεια.